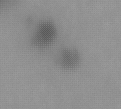

Solobservationer: astronomi på dagtid
Solobservationer är lite av en nischad sektion inom hobbyastronomin, av någon konstig anledning så faller Solen lite i skymundan i sammanhanget. Vi har en möjlighet till att observera denna stjärna i detalj, men ändå framstår de avlägsna som mer intressanta för många av oss.
Skälet till varför jag behandlar ämnet, är att jag vill lyfta fram solobservationens fördelar. Det är den enda astronomiform som kan utföras på dagtid, och är en observations form där det är mycket enkelt att fastställa konkret data med en vetenskaplig grund.
Ständig aktivitet, skapar variation i observationerna
Till skillnad från de planetära observationerna, så bjuder solen oss ständig aktivitet. Ibland kan man nästan observara uppkosten av solfläckar i realtid. ”reala i den mån, att något faktiskt sker inom loppet av några timmar”.
Solens aktiveter April månad, 2026
Ett förtydligande av grafen ovan
Presentation av data är den besvärliga biten, jag är av den åsikten att informationen ska framstå som begriplig för alla; annars förlorar den sin funktionaliten. Förstår mig inte på poängen med att ta fram information som begränsas till en specifik grupp av människor.
Jag bara hoppas att jag har lyckats att framställa något som fungerar, personligen tycker jag att denna graf ger en bra aktivitets överblick utan att komplicera till det i onödan. En Intressant avikelsen sker 2026-04-09, där vi tydligt ser att mänden H-fläckar överstiger A-klassen i antal, trotts att grupperings mängden är relativt hög.
Kategorisering av solfläckar
Uplägget är i grunden ganaka enkel, kategorisering stäcker sig från A till H i sitt grund utförande. Men så som med allt annat som berör forksning / vetenskap, så ska det kompliceras och utökas med tiden.
Men nu vi håller till min variant som är betydligt enklare 🙂 där vi endast använder oss av A-klassen, H-klassen och en grupperings klass….vi ska inte göra det krångligare än vad det behöver vara.
H-klass

En enskild stor solfläck, större än vår planet i diameter.
A-klass
Små solfläckar, dessa kan förekomma enskillt men oftast så ses de i grupperingar.
B-klass (en gruppering)

En eller flertal H-klass omgiven av flertal A-klasser, därav benämningen gruppering.



